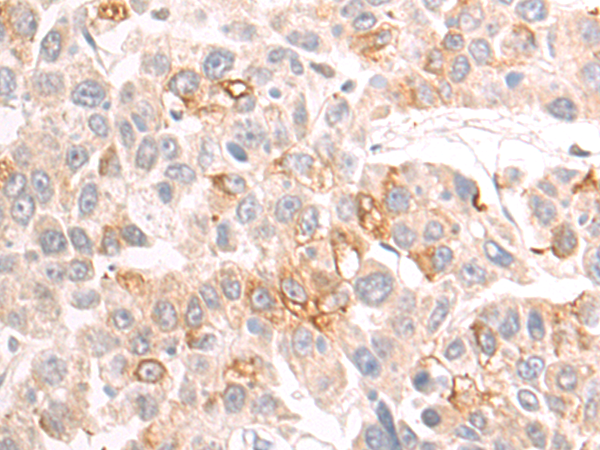

-
分类: 科研抗体货号: P03693别名: MPFYVE应用: WB,IHC反应种属: Human
-
分类: 科研抗体货号: P03662别名: CHIP; SCA48; UBOX1; SCAR16; HSPABP2; NY-CO-7; SDCCAG7应用: WB,IHC反应种属: Human, Mouse
-
分类: 科研抗体货号: P03691别名: PPP1R69应用: IHC反应种属: Human
-
分类: 科研抗体货号: P03661别名: LIMK; LIMK-1应用: WB,IHC反应种属: Human, Mouse, Rat
-
分类: 科研抗体货号: P03688别名: HIP3; HYPH; HIP14; HSPC294应用: WB反应种属: Human, Mouse, Rat
-
分类: 科研抗体货号: P03660别名: HTKL; EPLG5; Htk-L; LERK5应用: WB,IHC反应种属: Human, Mouse
-
分类: 科研抗体货号: P03686别名: ZF; SMILE应用: WB,IHC反应种属: Human, Mouse
-
分类: 科研抗体货号: P03708别名: ACT; AACT; GIG24; GIG25应用: WB,IHC反应种属: Human
-
分类: 科研抗体货号: P03685别名: LRF; FBI1; FBI-1; ZBTB7; ZNF857A; pokemon应用: WB反应种属: Human, Mouse, Rat
-
分类: 科研抗体货号: P03707别名: 5-HT4; 5-HT4R应用: WB反应种属: Human, Mouse, Rat

鄂公网安备42018502007531号
鄂公网安备42018502007531号

